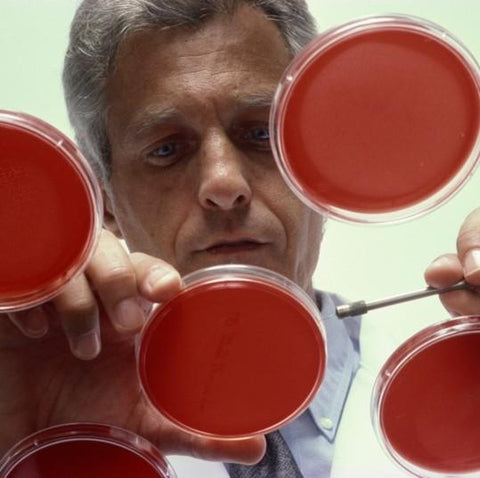

Research PKD
Half hour of research
Problem
Polycystic kidney disease (ADPKD) is one of the most common, life-threatening genetic diseases, affecting 600,000 Americans and 12.5 million people, worldwide. ADPKD affects more people than Down syndrome, cystic fibrosis, muscular dystrophy and sickle cell anemia combined. PKD causes fluid-filled cysts to grow on the kidneys. Over time, these cysts multiply and grow, causing kidney failure in 50 percent of cases. Dialysis and transplantation are the only treatment
The Gift
This gift will support vital PKD research funding aimed at finding a treatment and cure for PKD.